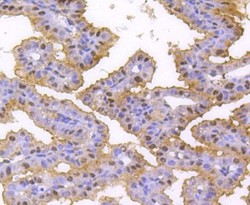

Antibody data
- Antibody Data
- Antigen structure
- References [0]
- Comments [0]
- Validations
- Western blot [1]
- Immunohistochemistry [5]
- Flow cytometry [1]
Submit
Validation data
Reference
Comment
Report error
- Product number
- NBP2-67656 - Provider product page

- Provider
- Novus Biologicals
- Product name
- Rabbit Monoclonal hnRNP C1 + C2 Antibody
- Antibody type
- Monoclonal
- Description
- Protein A purified.
- Reactivity
- Human, Mouse, Rat, Zebrafish
- Host
- Rabbit
- Isotype
- IgG
- Vial size
- 100 ul
- Storage
- Store at 4C short term. Aliquot and store at -20C long term. Avoid freeze-thaw cycles.
No comments: Submit comment
Supportive validation
- Submitted by
- Novus Biologicals (provider)
- Main image

- Experimental details
- Western Blot: hnRNP C1 + C2 Antibody (SN0652) [NBP2-67656] - Analysis of hnRNP C1+C2 on different lysates using anti-hnRNP C1+C2 antibody at 1/1,000 dilution. Positive control: Lane 1: Hela Lane 2: MCF-7 Lane 3: HepG2
Supportive validation
- Submitted by
- Novus Biologicals (provider)
- Main image

- Experimental details
- Immunohistochemistry-Paraffin: hnRNP C1 + C2 Antibody (SN0652) [NBP2-67656] - Analysis of paraffin-embedded human breast carcinoma tissue using anti-hnRNP C1+C2 antibody. Counter stained with hematoxylin.
- Submitted by
- Novus Biologicals (provider)
- Main image

- Experimental details
- Immunohistochemistry-Paraffin: hnRNP C1 + C2 Antibody (SN0652) [NBP2-67656] - Analysis of paraffin-embedded mouse skin tissue using anti-hnRNP C1+C2 antibody. Counter stained with hematoxylin.
- Submitted by
- Novus Biologicals (provider)
- Main image

- Experimental details
- Immunohistochemistry-Paraffin: hnRNP C1 + C2 Antibody (SN0652) [NBP2-67656] - Analysis of paraffin-embedded mouse brain tissue using anti-hnRNP C1+C2 antibody. Counter stained with hematoxylin.
- Submitted by
- Novus Biologicals (provider)
- Main image

- Experimental details
- Immunohistochemistry-Paraffin: hnRNP C1 + C2 Antibody (SN0652) [NBP2-67656] - Analysis of paraffin-embedded human kidney tissue using anti-hnRNP C1+C2 antibody. Counter stained with hematoxylin.
- Submitted by
- Novus Biologicals (provider)
- Main image
- Experimental details
- Immunohistochemistry-Paraffin: hnRNP C1 + C2 Antibody (SN0652) [NBP2-67656] - Analysis of paraffin-embedded mouse placenta tissue using anti-hnRNP C1+C2 antibody. Counter stained with hematoxylin.
Supportive validation
- Submitted by
- Novus Biologicals (provider)
- Main image

- Experimental details
- Flow Cytometry: hnRNP C1 + C2 Antibody (SN0652) [NBP2-67656] - Analysis of Hela cells with hnRNP C1+C2 antibody at 1/50 dilution (red) compared with an unlabelled control (cells without incubation with primary antibody; black). Alexa Fluor 488-conjugated goat anti rabbit IgG was used as the secondary antibody